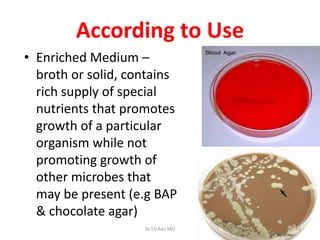
According to Use
• Enriched Medium –
broth or solid, contains
rich supply of special
nutrients that promotes
growth of a particular
organism while not
promoting growth of
other microbes that
may be present (e.g BAP
& chocolate agar)
Dr.T.V.Rao MD 41
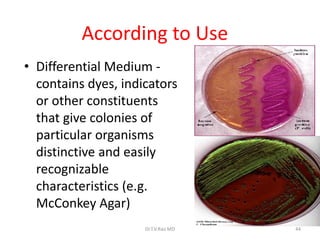
According to Use
• Differential Medium -
contains dyes, indicators
or other constituents
that give colonies of
particular organisms
distinctive and easily
recognizable
characteristics (e.g.
McConkey Agar)
Dr.T.V.Rao MD 44
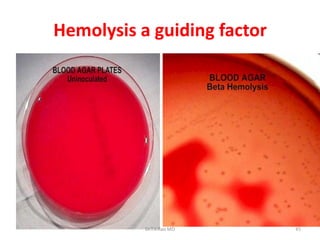
Hemolysis a guiding factor
Dr.T.V.Rao MD 45
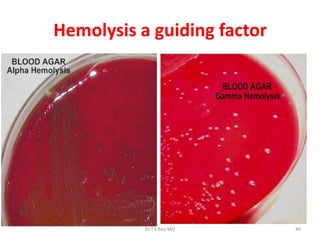
Hemolysis a guiding factor
Dr.T.V.Rao MD 46
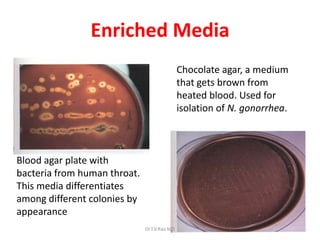
47
Enriched Media
Blood agar plate with
bacteria from human throat.
This media differentiates
among different colonies by
appearance
Chocolate agar, a medium
that gets brown from
heated blood. Used for
isolation of N. gonorrhea.
Dr.T.V.Rao MD
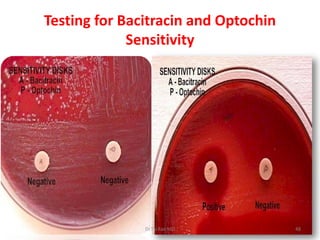
Testing for Bacitracin and Optochin
Sensitivity
Dr.T.V.Rao MD 48
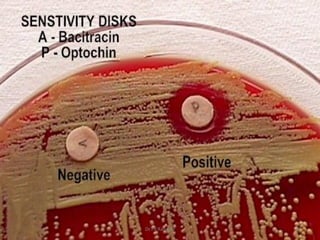
Dr.T.V.Rao MD 49
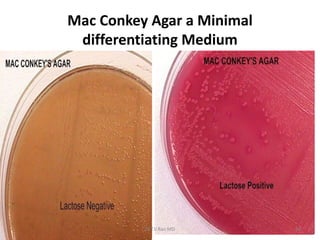
Mac Conkey Agar a Minimal
differentiating Medium
Dr.T.V.Rao MD 50
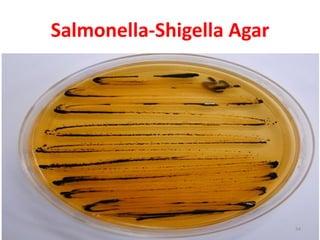
Salmonella-Shigella Agar
Dr.T.V.Rao MD 54
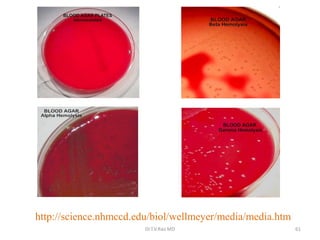
http://science.nhmccd.edu/biol/wellmeyer/media/media.htm
Dr.T.V.Rao MD 61
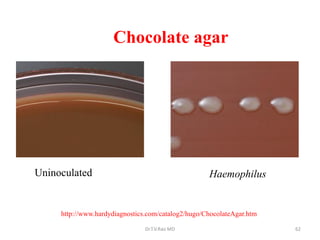
Chocolate agar
Uninoculated Haemophilus
http://www.hardydiagnostics.com/catalog2/hugo/ChocolateAgar.htm
Dr.T.V.Rao MD 62
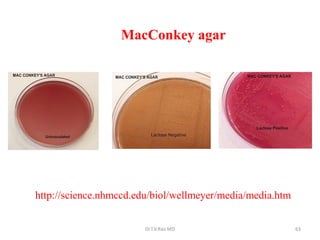
http://science.nhmccd.edu/biol/wellmeyer/media/media.htm
MacConkey agar
Dr.T.V.Rao MD 63
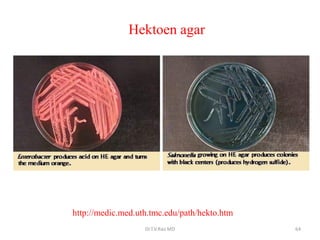
http://medic.med.uth.tmc.edu/path/hekto.htm
Hektoen agar
Dr.T.V.Rao MD 64
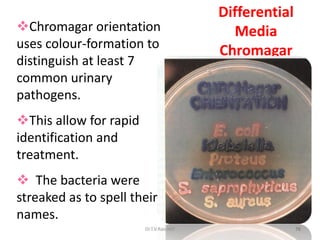
76
Differential
Media
Chromagar
Chromagar orientation
uses colour-formation to
distinguish at least 7
common urinary
pathogens.
This allow for rapid
identification and
treatment.
 The bacteria were
streaked as to spell their
names.
Dr.T.V.Rao MD

The document discusses methods for identifying bacterial pathogens. It describes three main categories of identification methods: phenotypic, immunological, and genotypic. Under phenotypic methods, it discusses microscopy techniques like Gram staining, acid-fast staining, and fluorescent staining. It also discusses culturing bacteria on different media like blood agar, MacConkey agar, and chocolate agar to examine colony morphology and biochemical characteristics. Successful identification relies on proper specimen collection, handling, and using techniques like microscopy, culture-based analysis, and immunological or molecular testing.